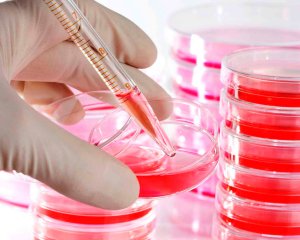
image

Заражение крови – это тяжелое состояние, развивающееся при проникновении в организм человека инфекционных возбудителей и токсических продуктов жизнедеятельности. Патологический процесс протекает остро и обычно начинает себя проявлять еще на начальной стадии, а также может носить гнойный и воспалительный характер.
Основными возбудителями сепсиса считаются различные виды бактерий, вирусов и грибков. При заражении крови симптомы и клиническая картина определяются видом инфекции и состоянием иммунитета организма человека.
Причины патологии
Чаще все сепсис возникает в результате проникновения в кровь бактериальных микроорганизмов
Сепсис может развиваться при внедрении в организм:
- кишечной палочки
- вируса герпеса
- пневмококков
- стафилококков
- менингококков
- микобактерии туберкулеза
Важную роль в развитии заболевания играет состояние иммунитета и его свойства. В том случае, если человек здоров и его иммунная система работает полноценно, то при попадании в кровь возбудителя она вовремя его обезвредит и не допустить заражения крови.
С учетом патогенного микроорганизма, который спровоцировал патологию, определяется и способ заражения. Существует такое понятие, как внутрибольничный сепсис, который начинает прогрессировать как результат плохо очищенного помещения и не стерильности инструментов. Микроорганизмы могут проникать в кровь человека оральным, отогенным, криптогенным и акушерско-гинекологическим путями. Кроме этого, инфицирование возможно через кожные покровы, при проведении операций и диагностических процедур.
Спровоцировать сепсис способны такие патологии, как сахарный диабет, рахит, ВИЧ, онкологические патологии и заболевания иммунной системы врожденного характера.
Отрицательно на здоровье пациента отражается прием медикаментов определенных групп и рентгенография, и они могут вызвать болезнь. В детском возрасте сепсис выявляется не так часто и обычно это происходит в период новорожденности.
Попадание возбудителей в организм ребенка может произойти еще во время его внутриутробного развития либо в ходе родовой деятельности. В том случае, если имеет место внутриутробное инфицирование, то кроха рождается на свет уже с проявлениями сепсиса. Заражение крови у маленьких детей преимущественно выявляется при попадании патогенных микроорганизмов через сосуды и пупочные ранки.
Врачи подчеркивают, что сепсис, как тяжелое инфекционное заболевание, требует немедленного внимания. Основные симптомы, на которые следует обратить внимание, включают резкое повышение температуры тела, озноб, учащенное сердцебиение и дыхание. Пациенты могут испытывать сильную слабость, спутанность сознания и снижение артериального давления. Важно отметить, что симптомы могут варьироваться в зависимости от возраста и общего состояния здоровья пациента. Врачи настоятельно рекомендуют не игнорировать эти признаки, так как своевременная диагностика и лечение могут спасти жизнь. При наличии подозрений на сепсис необходимо немедленно обратиться за медицинской помощью для проведения необходимых анализов и назначения терапии.

Признаки и симптомы заражения
Высокая температура, сильное потоотделение и лихорадка – первые признаки недуга
При сепсисе симптоматика зависит от вида микроорганизма, спровоцировавшего недуг, и состояния иммунитета. Клиническая картина включает в себя общие и специфические признаки, но в некоторых случаях патология может протекать бессимптомно.
Заподозрить недуг можно по следующим общим симптомам:
- повышение температуры до 40 градусов
- постоянная слабость
- усиленное потоотделение, сменяющееся ознобом
- увеличение размеров внутренних органов
- отсутствие аппетита, что вызывает потерю веса и даже развитие кахексии
- болевой синдром в мышцах и суставах
- различные виды сыпи, локализующиеся на коже
При заражении крови давление может падать до критических отметок, и вызывать развитие асептического шока с обмороками.
На самом деле, первые признаки заражения крови не всегда начинают появляться остро, то есть клиническая картина может развиваться медленно с постепенным повышением температуры тела и интоксикацией организма. Состояние больного за короткое время заметно ухудшается, то есть появляются проблемы с движениями. Исчезает желание кушать, и появляются трудности с выполнением какой-либо работы.
Возникновение специфических симптомов определяется причинным возбудителем, который спровоцировал недуг.
Больше информации о сепсисе можно узнать из видео:
С учетом такого фактора заражение крови имеет некоторые особенности:
- Для стафилококкового сепсиса характерно возникновение сильной боли в мышцах и подъем температуры тела. Кроме этого, образуются высыпания в виде пузырьков на коже больного. Первоначально состояние пациента довольно тяжелое, но при этом он находится в сознании. Одновременно с такой клинической картиной может появляться сухой кашель, который со временем дополняется появлением мокроты желтого цвета в большом объеме.
- Менингококковый сепсис характеризуется слишком стремительным развитием и состояние человека изначально тяжелое. Всего за несколько часов возможно развитие шока, и нередко такому состоянию предшествуют кровоизлияния в надпочечниках, что еще больше осложняет менингококковую инфекцию. Характерной особенностью такого вида сепсиса считается потеря сознания и появление на эпидермисе кровоизлияний различной формы.
- При пневмококковом заражении крови наблюдается появление таких симптомов, как подъем температуры тела до слишком высоких показателей, озноб и постоянная слабость, а также интоксикация организма и адинамия.
- При генерализованной пневмококковой инфекции пациент не падает в обмороки, и у него не развивается шок. Несмотря на тяжелое состояние организма, при таком виде инфицирования отсутствуют болевые ощущения в мышцах и сбои в функционировании органов, а также не появляется сыпь на коже. По сравнению с менингококковым заражением для пневмококкового инфицирования не свойственно слишком бурное течение.
- Грамотрицательный сепсис чаще всего развивается при иммунодефиците и бывает спровоцирован инфекцией, которая сопровождается появлением послеоперационных осложнений. Заражение крови после родовой деятельности чаще всего спровоцировано именно грамотрицательными микроорганизмами. При таком заражении наблюдается невысокая температура тела, и пациенты часто обращаются за медицинской помощью слишком поздно.
- Синегнойная форма сепсиса развивается на фоне проблем с работой иммунной системы. Она прогрессирует довольно стремительно и уже спустя несколько часов после подъема температуры тела может развиться шок.
Для инфекционного генерализованного процесса характерно появление герпетических пузырьков на кожных покровах вдоль ребер. Со временем они распространяются на другие участки эпидермиса, слизистую трахеи, бронхов, ротовой полости и пищевода.
Диагностика патологии
Бакпосев крови помогает определить возбудителей сепсиса
Для подбора терапевтических мероприятий по устранению сепсиса необходимо определить, каким образом возбудитель проник в организм. Лишь благодаря своевременной диагностике удается выявить на начальном этапе сепсис это или кратковременная инфекция.
Для постановки правильного диагноза важно учитывать определенные критерии болезни:
- проникновение патогенных микроорганизмов в большом объеме
- снижение защитных сил организма
- первичный очаг, взаимосвязанный с кровеносной и лимфатической системой
- появление вторичных очагов, из которых микроорганизмы также заражают кровь
Сепсис диагностируется на основе анамнеза больного, медицинского обследования и анализов крови на присутствие в ней возбудителей. Диагностические мероприятия включают анализ урины, спинномозговой жидкости, состава содержимого абсцесса и легочной слизи.
Заражение крови, или сепсис, вызывает серьезные опасения как у пациентов, так и у медицинских работников. Люди часто отмечают, что первые симптомы могут быть неочевидными: высокая температура, озноб и общая слабость. Однако со временем состояние может ухудшаться, добавляются такие признаки, как учащенное сердцебиение, затрудненное дыхание и спутанность сознания. Многие делятся историями о том, как игнорирование этих симптомов привело к тяжелым последствиям. Важно помнить, что сепсис может развиться на фоне любой инфекции, будь то простуда или более серьезное заболевание. Поэтому своевременное обращение к врачу и внимательное отношение к своему состоянию могут спасти жизнь. Обсуждая эту тему, люди подчеркивают необходимость повышения осведомленности о сепсисе и его симптомах, чтобы избежать трагических исходов.

Методы лечения
Лечение комплексное и включает антибактериальную, дезинтоксикационную и иммунотерапию
Сепсис является заболеванием, для которого характерен слишком высокий показатель смертности. Именно с учетом такого фактора лечение должно быть неотложным и проводиться в стационаре. Вероятность летального исхода высока в том случае, если патологический процесс охватывает большую часть органов и систем.
Основное лечение при заражении крови – это прием антибактериальных препаратов. Важно подобрать сильнодействующее лекарственное средство, которое соответствует чувствительности возбудителя.
Результат проводимой терапии зависит от стадии тяжести болезни, особенностей возбудителя и сопротивляемости организма.Кроме приема антибиотиков назначаются белковые медикаменты, проводится переливание крови, и вводятся специальные сыворотки.
Особое место в борьбе с заражением крови принадлежит высококалорийному питанию.
В детском возрасте устранение сепсиса предполагает еще местную терапию. Проводится обработка раны препаратами с антисептическим действием, удаляется гнойный экссудат и омертвевшие клетки. В том случае, если патология переходит в осложненную форму, то прибегают к интенсивной и хирургической терапии.
Возможные последствия
Сепсис может стать причиной летального исхода
При не проведении своевременной терапии заражения крови всегда развиваются множественные повреждения во всем организме, которые просто несовместимы с жизнью. При высокой чувствительности возбудителей к лечению и выраженном улучшении состояния антибактериальную терапию проводят около 2-3 недель. В том случае, если процесс затягивается и развиваются множественные осложнения, то лечение затягивается на несколько месяцев.
При позднем выявлении сепсиса и не проведении необходимого лечения возможно развитие гангрены конечностей и омертвление их тканей. Кроме этого, возможны необратимые изменения внутренних органов и кровоизлияния в надпочечники. К сожалению, такие осложнения считаются смертельно опасными.
Заражение крови считается тяжелым патологическим состоянием организма человека, которое требует своевременного и качественного лечения.
При своевременной терапии удается снизить температуру тела и очистить организм от скопившихся в нем токсинов. Спустя некоторое время проявления болезни исчезают, удается избежать развития осложнений и наступает выздоровление.
Заметили ошибку? Выделите ее и нажмите Ctrl+Enter, чтобы сообщить нам.

Вопрос-ответ
Как понять, что начался сепсис?
К распространенным проявлениям сепсиса относятся лихорадка, повышенная частота сердечных сокращений, учащенное дыхание, спутанность сознания и боли различной локализации. Сепсис может приводить к септическому шоку, полиорганной недостаточности и летальному исходу.
Что в крови указывает на сепсис?
Показатели СОЭ при сепсисе Скорость оседания эритроцитов, сокращенно СОЭ, характеризует скорость оседания эритроцитов под действием силы тяжести в крови, в которой искусственно заблокированы процессы свертывания (образования тромба). У мужчин этот показатель в норме составляет 2–15 мм/час, у женщин — 1–10 мм/час.
Можно ли заразиться сепсисом от другого человека?
Сепсис — это сочетание инфекции и чрезмерной реакции организма на нее. Во-первых, сепсисом нельзя заразиться.
Что чувствует человек при септическом шоке?
Сначала у человека наблюдается высокая (или низкая) температура тела, иногда озноб и слабость. В случае усиления сепсиса сердцебиение, как и дыхание, учащается, артериальное давление падает, наблюдается спутанность сознания.
Советы
СОВЕТ №1
Обратите внимание на ранние симптомы. Сепсис может проявляться через высокую температуру, озноб, учащенное сердцебиение и спутанность сознания. Если вы заметили у себя или у близкого человека эти признаки, не откладывайте обращение к врачу.
СОВЕТ №2
Следите за состоянием раны или инфекции. Если у вас есть открытая рана или инфекция, регулярно проверяйте ее на наличие покраснения, отека или гноя. Эти симптомы могут указывать на развитие сепсиса.
СОВЕТ №3
Не игнорируйте хронические заболевания. Люди с ослабленным иммунитетом или хроническими заболеваниями (например, диабетом или заболеваниями легких) находятся в группе риска. Обязательно консультируйтесь с врачом о том, как предотвратить инфекции и сепсис.
СОВЕТ №4
Обучитесь основам первой помощи. Знание того, как правильно обрабатывать раны и распознавать признаки инфекции, может помочь вам быстро реагировать на потенциальные угрозы и снизить риск развития сепсиса.